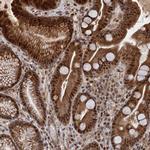
NEK8 Antibody in Immunohistochemistry (Paraffin) (IHC (P))

Search
Invitrogen
NEK8 Polyclonal Antibody
{{$productOrderCtrl.translations['antibody.pdp.commerceCard.promotion.promotions']}}
{{$productOrderCtrl.translations['antibody.pdp.commerceCard.promotion.viewpromo']}}
{{$productOrderCtrl.translations['antibody.pdp.commerceCard.promotion.promocode']}}: {{promo.promoCode}} {{promo.promoTitle}} {{promo.promoDescription}}. {{$productOrderCtrl.translations['antibody.pdp.commerceCard.promotion.learnmore']}}

Please note: We are reviewing Western blot images included in the antibody testing data in our catalog, including those provided by third parties. Unless expressly labeled or annotated as “raw-unedited”, Western blot images included in the antibody testing data in our catalog may have been edited, optimized or otherwise adjusted for presentation.
产品信息
PA5-111124
种属反应
宿主/亚型
分类
类型
抗原
偶联物
形式
浓度
规格
纯化类型
保存液
内含物
保存条件
运输条件
RRID
产品详细信息
Immunogen sequence: QPQPQFISRF LEGQSGVTIK HVACGDFFTA CLTDRGIIMT FGSGSNGCLG HGSLTDISQP TIVEALLGYE MVQVA
Highest antigen sequence indentity to the following orthologs: Mouse - 95%, Rat - 96%.
靶标信息
NEK8 serine/threonine kinase or NIMA-related kinase 8 is related to NIMA (never in mitosis, gene A) of Aspergillus nodulins and may play a role in cell cycle progression from G2 to M phase. NEK8 is part of a complex of ciliary proteins required for renal and cardiovascular development. NEK8 interacts with polycystin signal transduction pathways and may control the targeting of these ciliary proteins. Required for renal tubular integrity. May regulate local cytoskeletal structure in kidney tubule epithelial cells. May regulate ciliary biogenesis through targeting of proteins to the cilia.Defects in NEK8 are the cause of nephronophthisis type 9 (NPHP9) [MIM:613824]. NPHP9 is an autosomal recessive disorder resulting in end-stage renal disease. It is a progressive tubulo-interstitial kidney disorder histologically characterized by modifications of the tubules with thickening of the basement membrane, interstitial fibrosis and, in the advanced stages, medullary cysts.
仅用于科研。不用于诊断过程。未经明确授权不得转售。
篇参考文献 (0)
生物信息学
蛋白别名: NEK 8; Never in mitosis A-related kinase 8; Nima-related protein kinase 12a; NimA-related protein kinase 8; Serine/threonine-protein kinase Nek8
基因别名: JCK; NEK12A; NEK8
Entrez Gene ID: (Human) 284086




